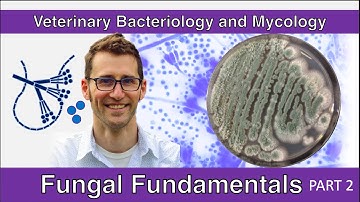
Fungal Fundamentals (Part 2) - Veterinary Bacteriology and Mycology

⬇ DOWNLOAD NOW
Kalau muncul iklan pop-up, tutup lalu klik tombol kembali
Download lagu Dermatophytes (Part 2) - Veterinary Bacteriology and Mycology secara gratis hanya untuk keperluan promosi. Dukung artis favorit kamu dengan membeli musik original di iTunes atau platform resmi lainnya.
 Dermatophytes (Part 1) - Veterinary Bacteriology and Mycology
Dermatophytes (Part 1) - Veterinary Bacteriology and Mycology
Fungal Fundamentals (Part 2) - Veterinary Bacteriology and Mycology
Fungal Fundamentals (Part 2) - Veterinary Bacteriology and Mycology
 Understanding dermatophytoses (ringworm)
Understanding dermatophytoses (ringworm)
 Dimorphic Fungi (Part 2) - Veterinary Bacteriology and Mycology
Dimorphic Fungi (Part 2) - Veterinary Bacteriology and Mycology
 Diagnostic Process (Part 2) - Veterinary Bacteriology and Mycology
Diagnostic Process (Part 2) - Veterinary Bacteriology and Mycology
![Superficial Fungal Infections: Dermatophytes Part 2 [Hot Topic]](https://i.ytimg.com/vi/ZSRMPjWA_PY/hqdefault.jpg?sqp=-oaymwEjCOADEI4CSFryq4qpAxUIARUAAAAAGAElAADIQj0AgKJDeAE=&rs=AOn4CLD8hsNyzr_isArhlvNOqxXh9YBD8Q) Superficial Fungal Infections: Dermatophytes Part 2 [Hot Topic]
Superficial Fungal Infections: Dermatophytes Part 2 [Hot Topic]
 Importance of Differentiating Fungal Species when Diagnosing Dermatophytosis
Importance of Differentiating Fungal Species when Diagnosing Dermatophytosis
 Fungal Fundamentals (Part 1) - Veterinary Bacteriology and Mycology
Fungal Fundamentals (Part 1) - Veterinary Bacteriology and Mycology